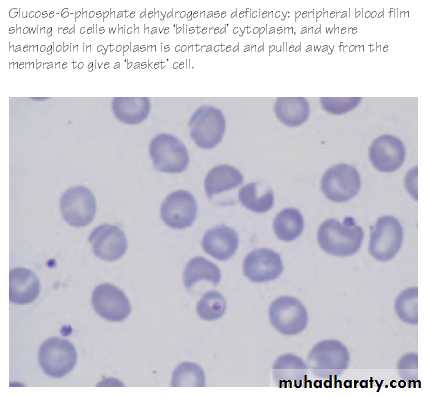

Glucose-6-Phosphate Dehydrogenase Deficiency
(G6PDD)The glycolytic pathway is the main source of energy (ATP)
The hexose monophosphate ‘shunt’ pathway provides the main source of reduced nicotinamide adenine dinucleotide phosphate (NADPH), which maintains reduced glutathione (GSH) and protects haemoglobin and the membrane proteins against oxidant damage.Genetics
1. Sex-linked recessive mode of inheritance by a gene located on the X chromosome (similar to hemophilia).2. Disease is fully expressed in hemizygous males and homozygous females.,there is an advantage of resistance to falciparum malaria in heterozygous females.
Pathogenesis
- Red cell integrity impaired, especially on exposure to oxidant drugs, oxidant response to infection and chemicals.• Oxidation of hemoglobin and of sulfhydryl groups in the membrane.
- Oxidized hemoglobin precipitates to form Heinz bodies which are plucked out of the red cell leading to hemolysis and “bite cell” and “blister cell” morphology.
WHO Classification of G6PD Variants
Clinical Features
Episodes of hemolysis may be produced by:• Drugs.
• Fava bean (broad bean): ingestion or exposure to pollen from the bean’s flower (favism)
• Infection.
symptoms develop 24–48 hr after a patient has ingested a substance that has oxidant properties, The degree of hemolysis varies with( the inciting agent, the amount ingested, and the severity of the enzyme deficiency). The enzyme is abundant and more stable in younger RBCs. The associated reticulocytosis produces a compensated hemolytic process.
PRECIPITATING FACTORS
Antimalarials: primaquine, quinine, chloroquineAntibiotics - nitrofuantoin, furazolidine,
cotrimoxazole, Nalidixic acid,
Chloramphenicol,
Others :
Vitamin K – large doses
Naphthalene (moth balls)
Benzene, Methylene blue
Probenecid
Acetyl salicylic acid (aspirin)
Fava beans
Septicemia and viral hepatitis
Diabetic ketoacidosis
1. Drug-induced hemolysis
a. Typically in African-Americans but also in Mediterranean types
c. Acute self-limiting hemolytic anemia with hemoglobinuria
d. Heinz bodies in circulating red cells
e. Blister cells, fragmented cells
f. Reticulocytosis
g. Hemoglobin normal between episodes.
2. Favism
This results from oxidative products derived from 2 glycosidic compounds, vicine and convicine, which are hydrolyzed to divicine and isouramil, ultimately producing hydrogen peroxide and other reactive oxygen products.Acute life-threatening hemolysis, often leading to acute renal failure, associated with Mediterranean.
Blood transfusion is required.
3. Neonatal jaundiceInfants may present with pallor, jaundice (can be severe and produce kernicterus)and dark urine. When a pregnant woman ingests oxidant drugs, they may be transmitted to her G6PD-deficient fetus, and hemolytic anemia and jaundice may be apparent at birth.
Occasionally exposure to naphthalene (mothballs), aniline dye, marking ink, or a drug.
Chronic nonspherocytic hemolytic anemia
Occurs mainly with sporadic inheritance it variable but can be severe with transfusion dependence, Intense neonatal presentation(NNJ)Persons with G6PD B‾(Mediterranean) enzyme deficiency occasionally have chronic hemolysis, and the hemolytic process may worsen after ingestion of oxidant drugs.
Splenectomy is of little value in these types of chronic hemolysis.
LABORATORY FINDINGS.
-Blood film:RBCs reveal Heinz bodies (precipitated hemoglobin.
Because cells containing these inclusions are rapidly removed from the circulation, they are not seen after the first 3–4 days of illness.
The blood film reveals a few fragmented and polychromatophilic cells (bluish, large RBCs), representing reticulocytosis(5–15%).
DIAGNOSIS
The diagnosis depends on direct or indirect demonstration of reduced G6PD activity in RBCs.By direct measurement,
enzyme activity in affected persons is ≤10% of normal. Immediately after a hemolytic episode, reticulocytes and young RBCs predominate. These young cells have significantly higher enzyme activity than do older cells. Testing may therefore have to be deferred for a few weeks before a diagnostically low level of enzyme can be shown.Satisfactory screening tests are based on - decoloration of methylene blue,
- reduction of methemoglobin- fluorescence of NADPH
G6PD variants also can be detected by electrophoretic analysis.
Treatment
1. Avoidance of agents that are deleterious in G6PD deficiency.2. Education of families and patients in recognition of food prohibition (fava beans), drug avoidance, heightened vigilance during infection and the symptoms and signs of hemolytic crisis (orange/dark urine, lethargy, fatigue, jaundice).
3. Indication for transfusion of packed red blood cell in children presenting with acute hemolytic anemia:
a. Hemoglobin (Hb) level below 7 g/dl
b. Persistent hemoglobinuria and Hb below 9 g/dl.
4. Chronic nonspherocytic hemolytic anemia (NSHA):
• In patients with severe chronic anemia: transfuse red blood cells to maintain Hb level (8–10 g/dl) and iron chelation when needed.